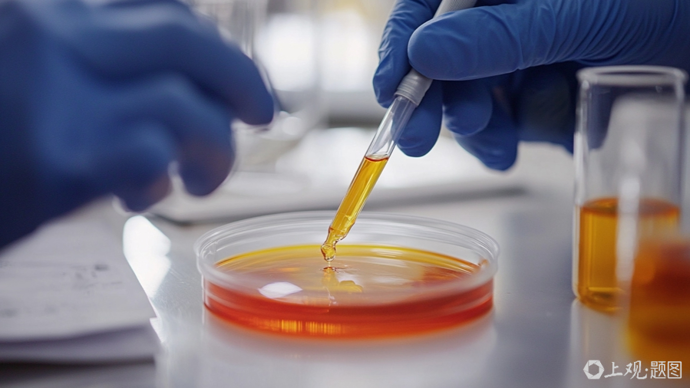

芬兰国家技术研究中心联合欧洲多国科研机构和企业,在一项最新科研项目中发现多种具有抗炎和抗衰老功效的植物基新成分,为可持续护肤品开发提供新方向。
由芬兰国家技术研究中心统筹实施的InnCoCells项目团队筛选了100多种植物提取物,评估其对20种与皮肤炎症和衰老相关的生物标志物的影响,最终确定约25种具有开发潜力的候选成分。这些成分可来源于温室中培育的植物,生物反应器中培养的植物细胞与组织,或经“变废为宝”再利用的农业副产物,兼具功效性与环境可持续性。
在发现的多种活性物质中,最引人注目的是丹麦岩荠的细胞培养物提取物,其具有显著的抗炎、抗衰老和抗菌活性;黄灯笼椒细胞培养物提取物能有效对抗有害皮肤细菌,甚至对超级细菌“耐甲氧西林金黄色葡萄球菌”也有抑制作用,并在无皮肤刺激性的情况下展现出强抗衰老活性;罗勒毛状根提取物则显示出抗胶原酶和抗透明质酸酶活性,有助于延缓皮肤老化、维持水分平衡。
项目团队表示,相关研究成果为新一代绿色可持续化妆品成分研发开辟了道路。目前,他们正探索商业模式与合作机制,推动相关植物基成分尽快进入市场应用阶段。
原标题:《新研究:从多种植物中提取抗炎抗衰新成分》
栏目主编:顾万全
文字编辑:高飞
本文作者:新华社
题图来源:上观题图
